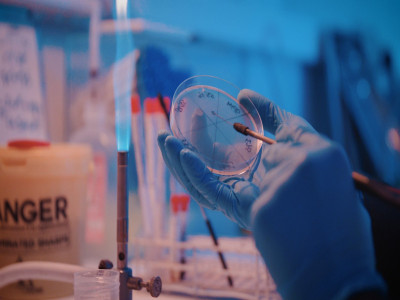
Savoir-faire

Nos services
Notre laboratoire s'engage à offrir des services d’analyses médicales précis, fiables et rapides, en s'appuyant sur des équipements de pointe et une équipe expérimentée, constamment formée aux dernières avancées technologiques et aux standards médicaux actuels.